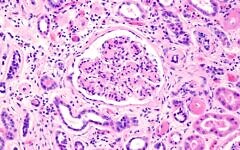

All the news about
microbiota
מה הקשר בין הרכב המיקרוביוטה לבין תהליכי התפתחות של נפרופתיה ממברנוטית?
08.05.2024

מה הקשר בין הרכב המיקרוביוטה לבין תהליכי התפתחות של נפרופתיה ממברנוטית?
01.05.2024

הרכב המיקרוביוטה במעי משפיעה על התגובה לנוגדי דיכאון
31.08.2023

ההשפעות של תרכובות עשבים אורגניות על חיידקי המעיים
קיימות תרכובות עשבים אורגניות בעלות השפעה פוטנטית מאוד
10.07.2023

הסטטוס האימונולוגי של סרטן מעי גס והמיקרוביוטה
השתלת מיקרוביוטה יכולה לסייע לשפר תגובה לאימונותרפיה בסרטן מעי גס
28.05.2023

שמן פצ’ולי והאפקט על מערכת החיסון והמיקרוביום
שמן פ'צולי חיוני נמצא בשימוש כריח למטרות טיפוליות רבות כבר מתקופת מצרים העתיקה
02.06.2022



